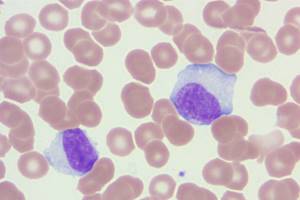

Тримек инструкция, аналоги и состав
| Показания: | Лікування інфекцій, збудники яких чутливі до цефтриаксону: інфекції дихальних шляхів, особливо пневмонія, а також інфекції вуха, горла і носа; інфекції органів черевної порожнини (перитоніт, інфекції жовчовивідних шляхів шлунково-кишкового тракту); інфекції нирок і сечовивідних шляхів; інфекції статевих органів, включаючи гонорею; сепсис; інфекції кісток, суглобів, м'яких тканин, шкіри, а також ранові інфекції; інфекції у хворих з ослабленим імунним захистом; менінгіт.Передопераційна профілактика інфекцій при хірургічних втручаннях на органах шлунково- кишкового тракту, жовчовивідних шляхів, сечовивідних шляхів і під час гінекологічних процедур, але лише у випадках потенційної чи відомої контамінації. При призначенні Тримеку необхідно дотримуватись офіційних рекомендацій з антибіотикотерапії, зокрема рекомендацій з профілактики антибіотикорезистентності. |
| Форма випуска: | Порошок для приготування розчину для ін'єкцій по 1 г у флаконах № 1 (пакування із форми in bulk фірми-виробника "СКС Лабораторіз", Індія) |
| Производитель, страна: | ТОВ "Авант", Україна |
| Действующее вещества: | 1 флакон містить цефтриаксону натрію еквівалентно цефтриаксону 1000 мг. |
| МНН: | Ceftriaxone - Цефтриаксон |
| Регистрация: | UA/12453/01/01з 06.09.2011 по 06.09.2016. Приказ 673 від 31.08.2012 |
| Код АТХ: |
Склад:
діюча речовина: сeftriaxone;
1 флакон містить цефтриаксону натрію еквівалентно цефтриаксону 1000 мг.
Лікарська форма. Порошок для приготування розчину для ін’єкцій.
Фармакотерапевтична група. Антибактеріальні засоби для системного застосування. Цефалоспорини. Код АТС J01D D04.
Клінічні характеристики.
Показання.Лікування інфекцій, збудники яких чутливі до цефтриаксону:
- інфекції дихальних шляхів, особливо пневмонія, а також інфекції вуха, горла і носа;
- інфекції органів черевної порожнини (перитоніт, інфекції жовчовивідних шляхів шлунково-кишкового тракту);
- інфекції нирок і сечовивідних шляхів;
- інфекції статевих органів, включаючи гонорею;
- сепсис;
- інфекції кісток, суглобів, м'яких тканин, шкіри, а також ранові інфекції;
- інфекції у хворих з ослабленим імунним захистом;
- менінгіт.
Передопераційна профілактика інфекцій при хірургічних втручаннях на органах шлунково-
кишкового тракту, жовчовивідних шляхів, сечовивідних шляхів і під час гінекологічних
процедур, але лише у випадках потенційної чи відомої контамінації.
При призначенні Тримеку необхідно дотримуватись офіційних рекомендацій з антибіотикотерапії, зокрема рекомендацій з профілактики антибіотикорезистентності.
Протипоказання.
Підвищена чутливість до цефалоспоринів. При наявності у хворого підвищеної чутливості до пеніциліну слід врахувати можливість перехресної алергічної реакції до препарату.
Препарат протипоказаний недоношеним дітям віком 41 тиждень із врахуванням строку внутрішньоутробного розвитку (гестаційний вік + вік після народження).
Гіпербілірубінемія у новонароджених та недоношених. У дослідженнях in vitro було показано, що цефтриаксон може витісняти білірубін із зв'язку з альбуміном сироватки крові, що може призвести до ризику розвитку енцефалопатії, спричиненої білірубіном.
Препарат протипоказаний новонародженим віком ≤ 28 днів для застосування при необхідності (чи очікуваній необхідності) лікування внутрішньовенними розчинами, які містять кальцій, у тому числі внутрішньовенні вливання, які містять кальцій, наприклад, парентеральне харчування, у зв'язку з ризиком виникнення преципітатів кальцієвих солей цефтриаксону (див. "Спосіб застосування та дози").
У новонароджених та недоношених дітей описані випадки виникнення преципітатів у легенях та нирках, які спричинили летальні наслідки при одночасному введенні цефтриаксону та препаратів кальцію. У деяких із цих випадків застосовувалися ті ж самі інфузійні системи для внутрішньовенного введення для препарату та розчинів, які містять кальцій, і в деяких інфузійних системах для внутрішньовенного введення спостерігалося виникнення преципітатів.
Ні в якому разі не можна застосовувати цефтриаксон з кальцієвмісними розчинами (розчин Рінгера тощо). Кальцієвмісні розчини не слід призначати протягом 48 годин після останнього введення цефтриаксону.
Спосіб застосування та дози.
Дорослі і діти старше 12 років: зазвичай призначають 1-2 г препарату 1 раз на добу (кожні 24 години). При тяжких інфекціях або інфекціях, збудники яких мають лише помірну чутливість до цефтриаксону, добову дозу можна збільшувати до 4 г.
Діти
Новонароджені, немовлята і діти віком до 12 років
Новонароджені (до 2 тижнів): 20-50 мг/кг маси тіла 1 раз на добу. Зважаючи на недорозвиненість ферментної системи, добова доза не повинна перевищувати 50 мг/кг маси тіла. При визначенні дози препарату для доношених і недоношених дітей відмінностей немає. Препарат протипоказаний для застосування новонародженим віком ≤ 28 днів при необхідності (чи очікуваній необхідності) лікування внутрішньовенними розчинами, які містять кальцій, у тому числі внутрішньовенні вливання, які містять кальцій, наприклад, парентеральне харчування, у зв'язку з ризиком виникнення преципітатів кальцієвих солей цефтриаксону.
Діти віком від 15 днів до 12 років: 20-80 мг/кг маси тіла 1 раз на добу. Дітям з масою тіла понад 50 кг призначають дози для дорослих.
Внутрішньовенні дози 50 мг/кг або вищі слід вводити шляхом інфузії протягом принаймні 30 хвилин.
Хворі літнього віку
Хворим літнього віку корекція дози не потрібна.
Тривалість лікування
Тривалість лікування залежить від перебігу хвороби. Як прийнято при терапії антибіотиками, хворим слід продовжувати приймати препарат ще протягом як мінімум 48-72 годин після того, як температура нормалізується і аналізи покажуть відсутність збудників.
Комбінована терапія
Відносно багатьох грамнегативних бактерій існує синергізм між препаратом і аміноглікозидами. Незважаючи на те, що підвищену ефективність таких комбінацій не завжди можна передбачити, їі слід мати на увазі при наявності тяжких, загрозливих для життя інфекцій, спричинених Рsеudоmоnаs аеrugіnоsа. Через фізичну несумісність цефтриаксону та аміноглікозидів їх слід вводити окремо в рекомендованих дозах.
Дозування в особливих випадках
Менінгіт
При бактеріальному менінгіті у дітей віком до 12 років лікування розпочинають з дози 100 мг/кг (але не більше 4 г) 1 раз на добу. Як тільки збудник буде ідентифікований, а його чутливість визначена, дозу можна відповідно знизити. Найкращі результати досягалися при такій тривалості лікування:
Neisseria meningitidis 4 дні
Наеторhilиs іпjlиеnzае 6 днів
Streptococcus рпеитопіае 7 днів
Гонорея
Для лікування гонореї (спричиненої утворюючими і неутворюючими пеніциліназу штамами) рекомендується призначати разову дозу 250 мг внутрішньом'язово.
Профілактика інфекцій у хірургії
Для профілактики післяопераційних інфекцій у хірургії рекомендується - залежно від ступеня небезпеки зараження - вводити разову дозу 1-2 г препарату за 30-90 хвилин до початку операції. При операціях на товстій і прямій кишці добре зарекомендувало себе одночасне (але окреме) введення препарату і одного з 5-нітроімідазолів, наприклад, орнідазолу.
Ниркова та печінкова недостатність
Хворим із порушеннями функції нирок немає необхідності знижувати дозу в тому випадку, якщо функція печінки залишається нормальною.
Хворим із порушеннями функції печінки немає необхідності знижувати дозу в тому випадку, якщо функція нирок залишається нормальною. Лише у разі ниркової недостатності в передтермінальній стадії (кліренс креатиніну менше 10 мл/хв) добова доза не повинна перевищувати 2 г. У хворих із порушеннями функції печінки немає необхідності знижувати дозу в тому випадку, якщо функція нирок залишається нормальною. При одночасній тяжкій нирковій та печінковій недостатності слід регулярно визначати концентрацію цефтриаксону у плазмі крові та проводити корекцію дози препарату у разі необхідності.
Хворим, які перебувають на гемодіалізі, немає потреби в додатковому введенні препарату після діалізу. Слід однак контролювати концентрацію цефтриаксону в сироватці крові на предмет можливої корекції дози, оскільки у цих хворих може знижуватися швидкість виведення. Добова доза препарату у хворих, які перебувають на гемодіалізі, не повинна перевищувати 2 г.
Приготування розчинів
Готувати розчини безпосередньо перед їх застосуванням.
Свіжоприготовлені розчини зберігають свою фізичну і хімічну стабільність протягом 6 годин при кімнатній температурі (або протягом 24 годин при температурі 2-8 °С). Залежно від концентрації і тривалості зберігання колір розчинів може варіювати від блідо-жовтого до бурштинового. Ця властивість активної речовини не впливає на ефективність або переносимість препарату.
Внутрішньом'язова ін'єкція
Для внутрішньом'язової ін'єкції 1 г розчиняють у 3,5 мл 1 % розчину лідокаїну, ін'єкцію роблять глибоко у сідничний м'яз. Рекомендується вводити не більше 1 г в одну сідницю. Розчин, що містить лідокаїн, не можна вводити внутрішньовенно.
Внутрішньовенна ін'єкція
Для внутрішньовенної ін'єкції розчиняють 1 г препарату в 10 мл стерильної води для ін'єкцій; вводять внутрішньовенно повільно (2-4 хвилини).
Внутрішньовенне вливання
Внутрішньовенне вливання має тривати не менше 30 хвилин. Для приготування розчину для вливання розчиняють 2 г препарату в 40 мл одного з наступних інфузійних розчинів, вільних від іонів кальцію: 0,9 % хлорид натрію, 0,45 % хлорид натрію + 2,5 % глюкоза, 5% глюкоза, 10 % глюкоза, 6 % декстран у розчині глюкози 5 %, 6-10 % гідроксіетильований крохмаль, вода для ін'єкцій. Зважаючи на можливу несумісність, розчини, які містять препарат, не можна змішувати з розчинами, які містять інші антибіотики, як при приготуванні, так і при введенні.
Не можна використовувати розчинники, які містять кальцій, такі як розчин Рінгера чи розчин Гартмана, для розчинення препарату у флаконах чи для розведення відновленого розчину для внутрішньовенного введення у зв'язку з вірогідністю утворення преципітатів кальцієвих солей цефтриаксону. Виникнення преципітатів кальцієвих солей цефтриаксону також може відбуватись при змішуванні препарату з розчинами, які містять кальцій в одній інфузійній системі для внутрішньовенного введення. Препарат не можна одночасно вводити внутрішньовенно з розчинами, які містять кальцій, у тому числі з тривалими інфузіями, які містять кальцій, наприклад, парентеральне харчування (див. "Взаємодія з іншими лікарськими засобами та інші види взаємодій").
Побічні реакції.
|
Частота побічних реакцій |
|
|
дуже поширені |
> 1/10 |
|
поширені |
> 1/100, < 1/10 |
|
непоширені |
> 1/1000, < 1/100 |
|
рідко поширені |
> 1/10000, < 1/1000 |
|
дуже рідко поширені |
< 1/10000, включаючи одиничні повідомлення |
При застосуванні препарату можливі такі побічні явища, які регресували спонтанно або після відміни препарату.
Інфекції: поширені: мікоз статевих шляхів, вторинні грибкові інфекції та інфекції, спричинені
резистентними мікроорганізмами.
З боку системи крові: поширені – еозинофілія, лейкопенія, гранулоцитопенія, гемолітична анемія, тромбоцитопенія, збільшення протромбінового часу; рідко поширені – підвищення рівня креатиніну в сироватці крові; дуже рідко поширені – розлади коагуляції. Дуже рідко спостерігались випадки агранулоцитозу (<500/мм3), переважно після застосування загальної дози 20 г чи більше. Під час тривалого лікування слід регулярно контролювати картину крові. Повідомлялося про незначне подовження протромбінового часу.
З боку травної системи: поширені – діарея, нудота, блювання, стоматит, глосит; рідко поширені – панкреатит, що розвинувся, можливо, внаслідок обструкції жовчовивідних шляхів. Більшість із цих хворих мали фактори ризику застою у жовчовивідних шляхах, наприклад, лікування в анамнезі, тяжкі захворювання та повністю парентеральне харчування. При цьому не можна виключати роль преципітатів у розвитку панкреатиту, що утворилися під дією препарату в жовчовивідних шляхах; дуже рідко поширені – псевдомембранозний ентероколіт.
З боку печінки та жовчовивідних шляхів: дуже поширені – преципітати кальцієвої солі цефтриаксону у жовчному міхурі з відповідною симптоматикою у дітей, зворотний холелітіаз у дітей. Вказані явища рідко спостерігались у дітей; поширені – збільшення рівня печінкових ферментів у сироватці крові (АСТ, АЛТ, лужної фосфатази).
З боку шкіри: поширені – висипання, алергічний дерматит, свербіж, кропив'янка, набряки, екзантема; дуже рідко поширені – ексудативна мультиформна еритема (синдром Стівенса-Джонсона), токсичний епідермальний некроліз (синдром Лайєлла).
З боку нирок та сечовидільної системи: рідко поширені – олігурія, гематурія, глюкозурія; дуже рідко поширені – утворення конкрементів у нирках, головним чином у дітей віком від 3 років, які отримували великі добові дози препарату (~ 80 мг/кг на добу) або кумулятивні дози понад 10 г, а також які мали додаткові фактори ризику (обмежене вживання рідини, постільний режим). Утворення конкрементів у нирках може протікати безсимптомно або проявлятися клінічно, може спричинити ниркову недостатність, яка минає після припинення лікування препаратом.
Загальні розлади: рідко поширені – головний біль і запаморочення, пропасниця, озноб, а також анафілактичні або анафілактоїдні реакції.
У поодиноких випадках спостерігаються запальні реакції стінки вени. Їх можна уникнути, застосовуючи повільну ін'єкцію (2-4 хвилини).
Внутрішньом'язова ін'єкція без застосування лідокаїну болюча.
Взаємодія з кальцієм
Препарат не можна призначати одночасно чи змішувати з кальцієвмісними розчинами, навіть при застосуванні окремих інфузійних систем. Описана невелика кількість летальних випадків утворення преципітатів кальцієвих солей цефтриаксону у легенях та нирках новонароджених. У деяких випадках венозні доступи та період введення цефтриаксону та кальцієвмісних розчинів були різні.
Вплив на результати лабораторних аналізів.
У поодиноких випадках при лікуванні препаратом у хворих можуть відзначатися хибнопозитивні результати реакції Кумбса. Як і інші антибіотики, препарат може спричиняти хибно позитивний результат проби на галактоземію. Хибнопозитивні результати можуть бути отримані і при визначенні глюкози в сечі, тому під час лікування препаратом глюкозурію, при необхідності, слід визначати лише ферментним методом.
Передозування.
У разі передозування гемодіаліз чи перитонеальний діаліз не зменшать концентрації препарату. Специфічного антидоту не існує. Лікування передозування симптоматичне.
Застосування у період вагітності або годування груддю.
Цефтриаксон проникає через плацентарний бар'єр. Безпечність застосування цефтриаксону
для жінок у період вагітності не вивчалась.
У малих концентраціях цефтриаксон виділяється у грудне молоко. Тому при призначенні цефтриаксону у період лактації годування груддю необхідно припинити.
Діти.
Препарат застосовують у педіатричній практиці.
Особливості застосування.
Як і при застосуванні інших цефалоспоринів, при застосуванні препарату повідомлялося про випадки анафілактичних реакцій з летальним наслідком, навіть якщо у докладному анамнезі немає відповідних вказівок. При виникненні алергічних реакцій препарат слід одразу відмінити та призначити відповідне лікування.
Цефтриаксон може збільшувати протромбіновий час. У зв'язку з цим при підозрі на дефіцит вітаміну К необхідно визначати протромбіновий час.
На тлі застосування практично всіх антибактеріальних препаратів, у тому числі й цефтриаксону, можливе виникнення діареї, асоційованої з Clostridium difficile, від легкого ступеня тяжкості до коліту з летальним наслідком. Антибактеріальні препарати змінюють нормальну флору товстого кишечнику, що призводить до надмірного росту Clostridium difficile. Clostridium difficile продукує токсини А та В, які сприяють розвитку діареї, асоційованої з Clostridium difficile. Штами Clostridium difficile, які надмірно продукують токсини, спричиняють підвищену захворюваність та летальність, оскільки ці інфекції можуть бути резистентними до антимікробних засобів та потребувати колектомії. Діарею, асоційовану з Clostridium difficile, необхідно виключити у всіх пацієнтів під час застосування антибіотиків. Необхідно зібрати детальний медичний анамнез, оскільки діарея, асоційована з Clostridium difficile, може виникати протягом двох місяців після закінчення застосування антибактеріальних засобів.
При підозрі чи підтвердженні діареї, асоційованої з Clostridium difficile, необхідно відмінити антибіотикотерапію, яка не впливає на Clostridium difficile. За клінічними показаннями слід призначити відповідну кількість рідини та електролітів, білкових добавок, антибіотикотерапію, до якої чутлива Clostridium difficile, та хірургічне обстеження.
Протягом тривалого застосування препарату можливі труднощі у контролюванні нечутливих до препарату мікроорганізмів. У зв'язку з цим необхідний ретельний нагляд за пацієнтами. При виникненні суперінфекції необхідно вжити відповідні заходи.
Після застосування цефтриаксону зазвичай у дозах, що перевищують стандартні рекомендовані, при ультразвуковому дослідженні жовчного міхура можуть спостерігатися тіні, що помилково сприймаються за камені. Це преципітати кальцієвої солі цефтриаксону, що зникають після завершення чи припинення терапії препаратом. Подібні зміни рідко супроводжуються будь-якою симптоматикою. Але і в таких випадках рекомендується лише консервативне лікування. Якщо ці явища супроводжуються клінічною симптоматикою, то рішення про відміну препарату приймає лікар.
У хворих, яким вводили препарат, описано поодинокі випадки панкреатиту, що розвинувся, можливо, внаслідок обструкції жовчовивідних шляхів. Більшість із цих хворих мали фактори ризику застою у жовчовивідних шляхах, наприклад лікування в анамнезі, тяжкі захворювання та повністю парентеральне харчування. При цьому не можна виключати роль преципітатів у розвитку панкреатиту, що утворилися під дією препарату в жовчовивідних шляхах.
Цефтриаксон може витісняти білірубін зі зв'язку з альбуміном сироватки крові. У зв'язку з цим застосування препарату новонародженим з гіпербілірубінемією протипоказане (див. розділ "Протипоказання").
Слід виявляти обережність при застосуванні препарату хворим із нирковою недостатністю,
які одночасно отримують аміноглікозиди та діуретики.
Цефтриаксон не можна змішувати чи призначати одночасно з кальцієвмісними розчинами, навіть при введенні препаратів через різні інфузійні системи. У новонароджених та недоношених дітей описані випадки виникнення преципітатів у легенях та нирках, які спричинили летальний наслідок при одночасному введенні цефтриаксону та препаратів кальцію. Про випадки виникнення внутрішньосудинних преципітатів після одночасного застосування цефтриаксону з внутрішньовенними кальцієвмісними розчинами також повідомлялося у пацієнтів інших вікових груп. У зв'язку з цим не можна застосовувати кальцієвмісні розчини для внутрішньовенного введення новонародженим та пацієнтам інших вікових груп щонайменше протягом 48 годин після введення останньої дози препарату (див. розділ "Протипоказання").
Імуноопосередкована гемолітична анемія спостерігалась у пацієнтів, які отримували цефалоспорини, у тому числі даний препарат. Про випадки тяжкої гемолітичної анемії, у тому числі летальні, повідомлялося у пацієнтів дорослого віку та дітей. При розвитку анемії під час застосування цефтриаксону необхідно виключити анемію, спричинену цефтриаксоном, та відмінити препарат до встановлення етіології анемії.
Під час тривалого лікування слід регулярно контролювати картину крові.
У поодиноких випадках при лікуванні препаратом у хворих можуть відмічатися хибнопозитивні результати реакції Кумбса. Як і інші антибіотики, препарат може спричиняти хибнопозитивний результат проби на галактоземію. Хибнопозитивні результати можуть бути отримані і при визначенні глюкози у сечі, тому під час лікування препаратом глюкозурію, при необхідності, слід визначати лише ферментним методом.
Здатність впливати на швидкість реакції при керуванні автотранспортом або роботі з іншими механізмами.
Немає даних про вплив цефтриаксону на швидкість реакції, але у зв'язку з можливістю виникнення запаморочення препарат може впливати на здатність керувати транспортними засобами або працювати зі складними механізмами.
Взаємодія з іншими лікарськими засобами та інші види взаємодій.
Ні в якому разі не можна застосовувати препарат з кальцієвмісними розчинами (розчин Рінгера тощо). Кальцієвмісні розчини не слід призначати протягом 48 годин після останнього введення цефтриаксону.
У новонароджених та недоношених дітей описані випадки виникнення преципітатів у легенях та нирках, які спричинили летальні наслідки при одночасному введенні цефтриаксону та препаратів кальцію.
При одночасному застосуванні високих доз препарату і таких сильнодіючих діуретиків, як фуросемід, порушень функції нирок не спостерігалося. Немає вказівок на те, що препарат підвищує ниркову токсичність аміноглікозидів. Після вживання алкоголю одразу після прийому препарату не спостерігалося ефектів, схожих на дію дисульфіраму (тетураму). Цефтриаксон не містить N-метилтіотетразольну групу, яка б могла викликати непереносимість етанолу, а також кровотечі, що властиві деяким іншим цефалоспоринам. Пробенецид не впливає на виведення препарату.
Іn vitro був виявлений антагонізм між хлорамфеніколом та цефтриаксоном.
Не можна використовувати розчинники, які містять кальцій, такі як розчин Рінгера чи розчин Гартмана, для розчинення препарату у флаконах чи для розведення відновленого розчину для внутрішньовенного введення у зв'язку з вірогідністю утворення преципітатів кальцієвих солей цефтриаксону. Виникнення преципітатів кальцієвих солей цефтриаксону також може відбуватися при змішуванні препарату з розчинами, які містять кальцій, в одній інфузійній системі для внутрішньовенного введення. Препарат не можна одночасно вводити внутрішньовенно з розчинами, які містять кальцій, у тому числі з тривалими інфузіями, які містять кальцій, наприклад, парентеральне харчування (див. "Спосіб застосування та дози"). У дослідженнях іn vitro було показано, що у немовлят підвищений ризик утворення преципітатів кальцієвих солей цефтриаксону.
Є дані щодо несумісності цефтриаксону з амзакрином, ванкоміцином, флуконазолом та аміноглікозидами.
Бактеріостатичні засоби можуть впливати на бактерицидну дію цефалоспоринів. Цефтриаксон може зменшувати ефективність гормональних пероральних контрацептивів. У зв'язку з цим рекомендується застосовувати додаткові (негормональні) методи контрацепції під час лікування та протягом 1 місяця після лікування.
Немає повідомлень про взаємодію між цефтриаксоном та продуктами для перорального прийому, які містять кальцій, та взаємодію між цефтриаксоном при внутрішньом'язовій ін'єкції і продуктами, які містять кальцій (внутрішньовенно чи перорально).
Фармакологічні властивості.
Фармакодинаміка.
Тримек – парентеральний цефалоспориновий антибіотик ІІІ покоління з пролонгованою дією.
Мікробіологія
Бактерицидна активність цефтриаксону зумовлена пригніченням синтезу клітинних мембран. Цефтриаксон активний іn vitro відносно більшості грамнегативних і грампозитивних мікроорганізмів. Цефтриаксон характеризується дуже великою стійкістю до більшості β‑лактамаз (як пеніциліназ, так і цефалоспориназ) грампозитивних і грамнегативних бактерій. Цефтриаксон активний щодо таких мікроорганізмів іn vitro і при клінічних інфекціях (див. "Показання"):
Грампозитивні аероби.
Staphylococcus aureus (метициліночутливий), коагулазонегативні стафілококи, Streptococcus pyogenes (β-гемолітичний, групи А), Streptococcus agalactiae (β-гемолітичний, групи В), β‑гемолітичні стрептококи (групи ні А, ні В), Streptococcus viridans, Streptococcus рпеитопіае.
Примітка. Стійкі до метициліну Staphylococcus spp. резистентні до цефалоспоринів, у тому числі до цефтриаксону. Також Enterococcus faecalis, Enterococcus fаесіum та Listeria monocytogenes виявляють стійкість до цефтриаксону.
Грамнегативні аероби.
Acinetobacter lwoffi, Acinetobacter anitratus (головним чином А. bаumаnіі)*, Aeromonas hydrophila, Alcaligenes faecalis, Alcaligenes odorans, алкагеноподібні бактерії, Воrrеlіа burgdorferi, Capnocytophaga spp., Citrobacter diversus (в тому числі С. amalonaticus), Citrobacter freundii*, Escherichia соІі, Enterobacter aerogenes*, Enterobacter сlоасае*, Enterobacter spp. (інші)*, Haemophilus ducreyi, Haemophilus injluenzae, Haemophilus parainjluenzae, Hafnia alvei, Klebsiella охуіоса, Klebsiella рnеumоnіае**, Moraxella catarrhalis(раніше називалися Branhamella catarrhalis), Moraxella оslоеnsіs, Moraxella spp. (інші), Morganella morganii, Neisseria gonorrhoea, Neisseria meningitidis,Раstеurеllа multосіdа,Рlеsіоmоnаs shigelloides,Рrоtеus mirabilis,Рrоtеus penneri*, Рrоtеus vulgаrіs*, Рsеudоmоnаs fluorescens*, Pseudomonas spp. (інші)*, Providentia rettgeri*, Providentia spp. (інші), Salmonella typhi, Salmonella spp. (нетифоїдні), Serratia marcescens*, Serratia spp. (інші)*, Shigella spp., Vibrio spp., Yersinia еntеrосоlіtіса, Yersinia spp. (інші).
* деякі ізоляти цих видів стійкі до цефтриаксону головним чином унаслідок утворення β‑лактамаз, що кодуються хромосомами.
* * деякі ізоляти цих видів стійкі до цефтриаксону унаслідок утворення низки плазмідоопосередкованих β-лактамаз.
Примітка. Багато з штамів вищезазначених мікроорганізмів, які мають множинну стійкість до таких антибіотиків, як амінопеніциліни та уреїдопеніциліни, цефалоспорини першого та другого покоління, аміноглікозиди, є чутливими до цефтриаксону. Treponema раllidum чутлива до цефтриаксону іn vitro і в дослідах на тваринах. Клінічні випробування показують, що цефтриаксон ефективний для лікування первинного і вторинного сифілісу, за винятком клінічних штамів Р. Аеrugіnоsа, стійких до цефтриаксону.
Анаероби.
Bacteroides spp. (чутливі до жовчі)*, Clostridium spp. (крім С. difficile), Fusobacterium nucleatum, Fusobacterium spp. (інші), Gaffkia anaerobica (раніше називалися Peptococcus), Рерtоstгерtососсus spp.
* деякі ізоляти цих видів стійкі до цефтриаксону внаслідок утворення β-лактамаз.
Примітка. Багато з штамів Bacteroides spp., які продукують β-лактамази (зокрема, В. fragilis), стійкі до цефтриаксону. Стійкий Clostridium difficile.
Для визначення чутливості мікроорганізмів слід використовувати диски з цефтриаксоном, оскільки цефтриаксон активний відносно окремих штамів, які стійкі при використанні дисків, призначених для всієї групи цефалоспоринів.
Замість стандартів НККЛС для визначення чутливості мікроорганізмів можна використовувати й інші добре стандартизовані нормативи, наприклад DIN та ICS, що дозволяють адекватно оцінити рівень чутливості.
Фармакокінетика.
Фармакокінетика цефтриаксону має нелінійний характер. Всі основні фармакокінетичні параметри, що базуються на загальних концентраціях препарату, за винятком періоду напіввиведення, залежать від дози.
Всмоктування
Максимальна концентрація у плазмі крові після одноразового внутрішньом'язового введення 1 г препарату становить 81 мг/л та досягається за 2-3 години після введення. Площа під кривою концентрації у плазмі крові після внутрішньовенного введення дорівнює такій після внутрішньом'язового введення. Це означає, що біодоступність цефтриаксону після внутрішньом'язового введення становить 100 %.
Розподіл
Об'єм розподілу цефтриаксону становить 7-12 л. Після введення у дозі 1-2 г цефтриаксон добре проникає у тканини та рідини організму. Протягом більш ніж 24 години його концентрації набагато перевищують мінімальні пригнічувальні концентрації для більшості збудників інфекцій більш ніж у 60 тканинах та рідинах (у тому числі легенях, серці, жовчовивідних шляхах, печінці, мигдаликах, середньому вусі та слизовій носа, кістках, а також спинномозковій, плевральній та синовіальній рідинах, у секреті простати).
Після внутрішньовенного введення цефтриаксон швидко проникає у спинномозкову рідину, де бактерицидні концентрації щодо чутливих мікроорганізмів зберігаються протягом 24 годин.
Зв'язування з білками
Цефтриаксон зворотно зв'язується з альбуміном зі зростанням концентрації у плазмі крові.
Проникнення в окремі тканини
Цефтриаксон проникає через запалені мозкові оболонки у дітей, у т.ч. новонароджених. Через 24 години після внутрішньовенного введення препарату в дозі 50-100 мг/кг маси тіла (новонародженим та немовлятам відповідно) концентрації цефтриаксону у спинномозковій рідині перевищують 1,4 мг/л. Максимальна концентрація у спинномозковій рідині досягається приблизно через 4 години після внутрішньовенного введення та становить у середньому 18 мг/л. При бактеріальному менінгіті середня концентрація цефтриаксону в цереброспінальній рідині становить 17 % від концентрації у плазмі крові, при асептичному менінгіті – 4 %. У дорослих хворих на менінгіт після введення дози 50 мг/кг маси тіла через 2-24 години досягаються такі концентрації цефтриаксону у цереброспінальній рідині, які в багато разів перевищують мінімальні інгібуючі концентрації для найрозповсюдженіших збудників менінгіту.
Цефтриаксон проходить через плацентарний бар'єр та в малих концентраціях виділяється у грудне молоко.
Метаболізм
Цефтриаксон не піддається системному метаболізму, а перетворюється у неактивні метаболіти під дією кишкової флори.
Виведення
Загальний плазмовий кліренс цефтриаксону дорівнює 10-22 мл/хв. Нирковий кліренс дорівнює 5-12 мл/хв. 50-60 % цефтриаксону виводиться у незміненому вигляді нирками і 40-50 % – у незміненому вигляді з жовчю. Період напіввиведення цефтриаксону у дорослих становить близько 8 годин.
Фармакокінетика в особливих клінічних випадках
У новонароджених дітей нирками виводиться приблизно 70 % дози. У дітей перших 8 днів життя, а також у пацієнтів старше 75 років період напіввиведення у середньому в 2-3 рази більший, ніж у дорослих молодого віку.
У хворих із нирковою або печінковою недостатністю фармакокінетика цефтриаксону змінюється незначною мірою, відзначається лише незначне збільшення періоду напіввиведення. Якщо порушена лише функція нирок – збільшується виведення з жовчю, якщо порушена функція печінки – збільшується виведення нирками.
Фармацевтичні характеристики.
Основні фізико-хімічні властивості: порошок білого або майже білого кольору.
Несумісність.
Цефтриаксон не можна змішувати з кальцієвмісними розчинами, такими як розчин Рінгера чи розчин Гартмана.
Цефтриаксон несумісний з амсакрином, ванкоміцином, флуконазолом і аміноглікозидами.
Не слід змішувати з іншими розчинниками, крім тих, що зазначені в розділі "Спосіб застосування та дози".
Термін придатності.2 роки.
Умови зберігання. Зберігати при температурі не вище 25 °С у захищеному від світла та недоступному для дітей місці.
Приготовлений розчин зберігати не більше 6 годин при кімнатній температурі і не більше 24 годин при температурі 5 °С.
Упаковка. Порошок у скляних флаконах ємністю 10 мл, закупорених пробками і алюмінієвими ковпачками. На флакон наклеюють етикетку. По 1 флакону кладуть у коробку.
Категорія відпуску. За рецептом.
Виробник. ТОВ "АВАНТ", Україна (пакування із форми in bulk фірми-виробника "СКС Лабораторіз", Індія).
Місцезнаходження. Україна, 03057, м. Київ, вул. Ежена Потьє, 14.
Тел/факс: 044 496 19 94, e-mail: avant_pharm@ukr.net
Аналоги
Совпадает код ATХ + действующие вещества + форма випуска
| Международное название | Ceftriaxone - Цефтриаксон |
| Код АТХ | J01DD04 |
| Форма выпуска | порошок |
- ЦЕФОГРАМ® ОРХІД ХЕЛТХКЕР (відділення Орхід Кемікалс енд Фармасьютікалс Лімітед), Індія
- ЕМСЕФ® 1000 Нектар Лайфсайнсіз Лімітед, Індія
- ЦЕФАКСОН Люпін Лімітед, Індія
- БРЕСЕК АНФАРМ ХЕЛЛАС С.А/Фармацевтичний завод "Віанекс С.A."/Фармацевтичний завод "Анфарм Хеллас С.А.", Греція/Греція/Греція
- БРЕСЕК АНФАРМ ХЕЛЛАС С.А/Фармацевтичний завод "Віанекс С.A."/Фармацевтичний завод "Анфарм Хеллас С.А.", Греція/Греція/Греція
- ЛОРАКСОН Ексір Фармасьютикал Компані, Іран
- ЛОРАКСОН Ексір Фармасьютикал Компані, Іран
- ЦЕФТРИАКСОН НСПС Хебей Хуамін Фармасьютікал Компані Лімітед, Китай
- МЕДАКСОН Медокемі ЛТД (Завод С), Кіпр
- МЕДАКСОН Медокемі ЛТД (Завод С), Кіпр
- ЦЕФОГРАМ® ОРХІД ХЕЛТХКЕР (відділення Орхід Кемікалс енд Фармасьютікалс Лімітед), Індія
- ЦЕФТРІАКСОН-АСТРАФАРМ ТОВ "АСТРАФАРМ", Україна
- ЦЕФОГРАМ® ОРХІД ХЕЛТХКЕР (відділення Орхід Кемікалс енд Фармасьютікалс Лімітед), Індія
- ЦЕФТРИАКСОН Товариство з обмеженою відповідальністю "Фармацевтична компанія "Здоров'я", Україна
- ЦЕФТРИАКСОН Товариство з обмеженою відповідальністю "Фармацевтична компанія "Здоров'я", Україна
- ЦЕФТРИАКСОН АТ "Лекхім-Харків", Україна
- ЦЕФТРИАКСОН-ДАРНИЦЯ ПрАТ "Фармацевтична фірма "Дарниця", Україна
- ЦЕФТРИАКСОН-ДАРНИЦЯ ПрАТ "Фармацевтична фірма "Дарниця", Україна
- ЦЕФТРИАКСОН ТОВ "Авант", Україна
- ЦЕФТРИАКСОН ТОВ "Авант", Україна
- ЦЕФТРИАКСОН ТОВ "Авант", Україна
- ЦЕФТРИАКСОН Зейсс Фармас'ютікелс Пвт Лтд, Індія
- ЦЕФТРІАКСОН-АСТРАФАРМ ТОВ "АСТРАФАРМ", Україна
- РОТАЦЕФ Зентіва Саглик Урунлері Сан. ве Тідж. А.Ш., Туреччина
- РУМІКСОН ФАРМЮНІОН Антібіотіке С.А. (Виробник, відповідальний за вторинне пакування, тестування та випуск серій кінцевого продукту)/Шеньчжен Жиюн Фармасьютикал Ко. Лтд, Румунія/Китай
- РУМІКСОН ФАРМЮНІОН Антібіотіке С.А. (Виробник, відповідальний за вторинне пакування, тестування та випуск серій кінцевого продукту)/Шеньчжен Жиюн Фармасьютикал Ко. Лтд, Румунія/Китай
- РОТАЦЕФ Зентіва Саглик Урунлері Сан. ве Тідж. А.Ш., Туреччина
- КСОН ІН'ЄКЦІЇ 1 г Алкем Лабораторіз Лтд., Індія
- ЦЕФТРІАКСОН-БХФЗ Публічне акціонерне товариство "Науково-виробничий центр "Борщагівський хіміко-фармацевтичний завод", Україна
- ЦЕФТРІАКСОН-БХФЗ Публічне акціонерне товариство "Науково-виробничий центр "Борщагівський хіміко-фармацевтичний завод", Україна
- БЛІЦЕФ Блісс Біотек Пвт. Лтд./Аджіла Спесіалтіс Пвт. Лтд, Індія/Індія
- ТЕРЦЕФ® Балканфарма-Разград АТ, Болгарія
- ТЕРЦЕФ® Балканфарма-Разград АТ, Болгарія
- ЕМСЕФ® ЕМКЙОР ФАРМАСЬЮТІКАЛС ЛТД., Індія
- ЕМСЕФ® ЕМКЙОР ФАРМАСЬЮТІКАЛС ЛТД., Індія
- ЦЕФТРАКС Фармацевтична компанія Джабер Ібн Хайан, Іран
- ЦЕФТРІАКСОН ПАТ "Київмедпрепарат", Україна
- ЦЕФТРІАКСОН ПАТ "Київмедпрепарат", Україна
- Алвобак Лабораторіо Реіг Жофре, С.А., Іспанія
- Альцизон 1 г Зейсс Фармас`ютікелс Пвт Лтд, Індія
- Альцизон 2 г Зейсс Фармас`ютікелс Пвт Лтд, Індія
- Диацеф Аджіла Спесіалтіс Пвт. Лтд/Аджіла Спесіалтіс Пвт. Лтд, Індія/Індія
- Максон 1 г Зейс Фармас'ютікалс Пвт. Лтд., Індія
- Максон 500 мг Зейс Фармас'ютікалс Пвт. Лтд., Індія
- Процеф 0,5 г Товариство з обмеженою відповідальністю "Фармацевтична компанія "Здоров'я", Україна
- Процеф 1 г Товариство з обмеженою відповідальністю "Фармацевтична компанія "Здоров'я", Україна
- Роцефин Ф. Хоффманн-Ля Рош Лтд (Виробництво нерозфасованої продукції, пакування, випробування контролю якості, випуск серії), Швейцарія
- Тримек ТОВ "Авант", Україна
- Цефотаксим-Мип Хефасаар Хіміко-Фармацевтична Фабрика ГмбХ, Німеччина
- Цефтриаксон АТ "Лекхім-Харків", Україна
- Цефтриаксон ТОВ "Авант", Україна
- Цефтриаксон Жухай Юнайтед Лабораторіз (Жонгшан) Ко., Лтд., Китай
- Цефтриаксон ТОВ "Авант", Україна
- Цефтриаксон Зейсс Фармас'ютікелс Пвт Лтд, Індія
- Цефтриаксон Люпін Лімітед, Індія
- Цефтриаксон Каби Лабесфаль Лабораторіос Алміро, С.А., Португалія
- Цефтриаксон Каби 1000 мг Лабесфаль Лабораторіос Алміро, С.А., Португалія
- Цефтриаксон Каби 2000 мг Лабесфаль Лабораторіос Алміро, С.А., Португалія
- Цефтриаксон Каби 500 мг Лабесфаль Лабораторіос Алміро, С.А., Португалія
- Цефтриаксон-Фармекс 1 г ТОВ "ФАРМЕКС ГРУП", Україна
- Цефтриаксон-Фармекс 500 мг ТОВ "ФАРМЕКС ГРУП", Україна
- Эфмерин 1 г Астрал СтеріТек Прайвіт Лімітед, Індія
- Эфмерин 2 г Астрал СтеріТек Прайвіт Лімітед, Індія

 Синдром Віскотта-Олдрича
Синдром Віскотта-Олдрича
 Краснуха
Краснуха
Инфекционный мононуклеоз
Инфекционный мононуклеоз
 Cистемні прояви цирозу печінки вірусної етіології
Cистемні прояви цирозу печінки вірусної етіології